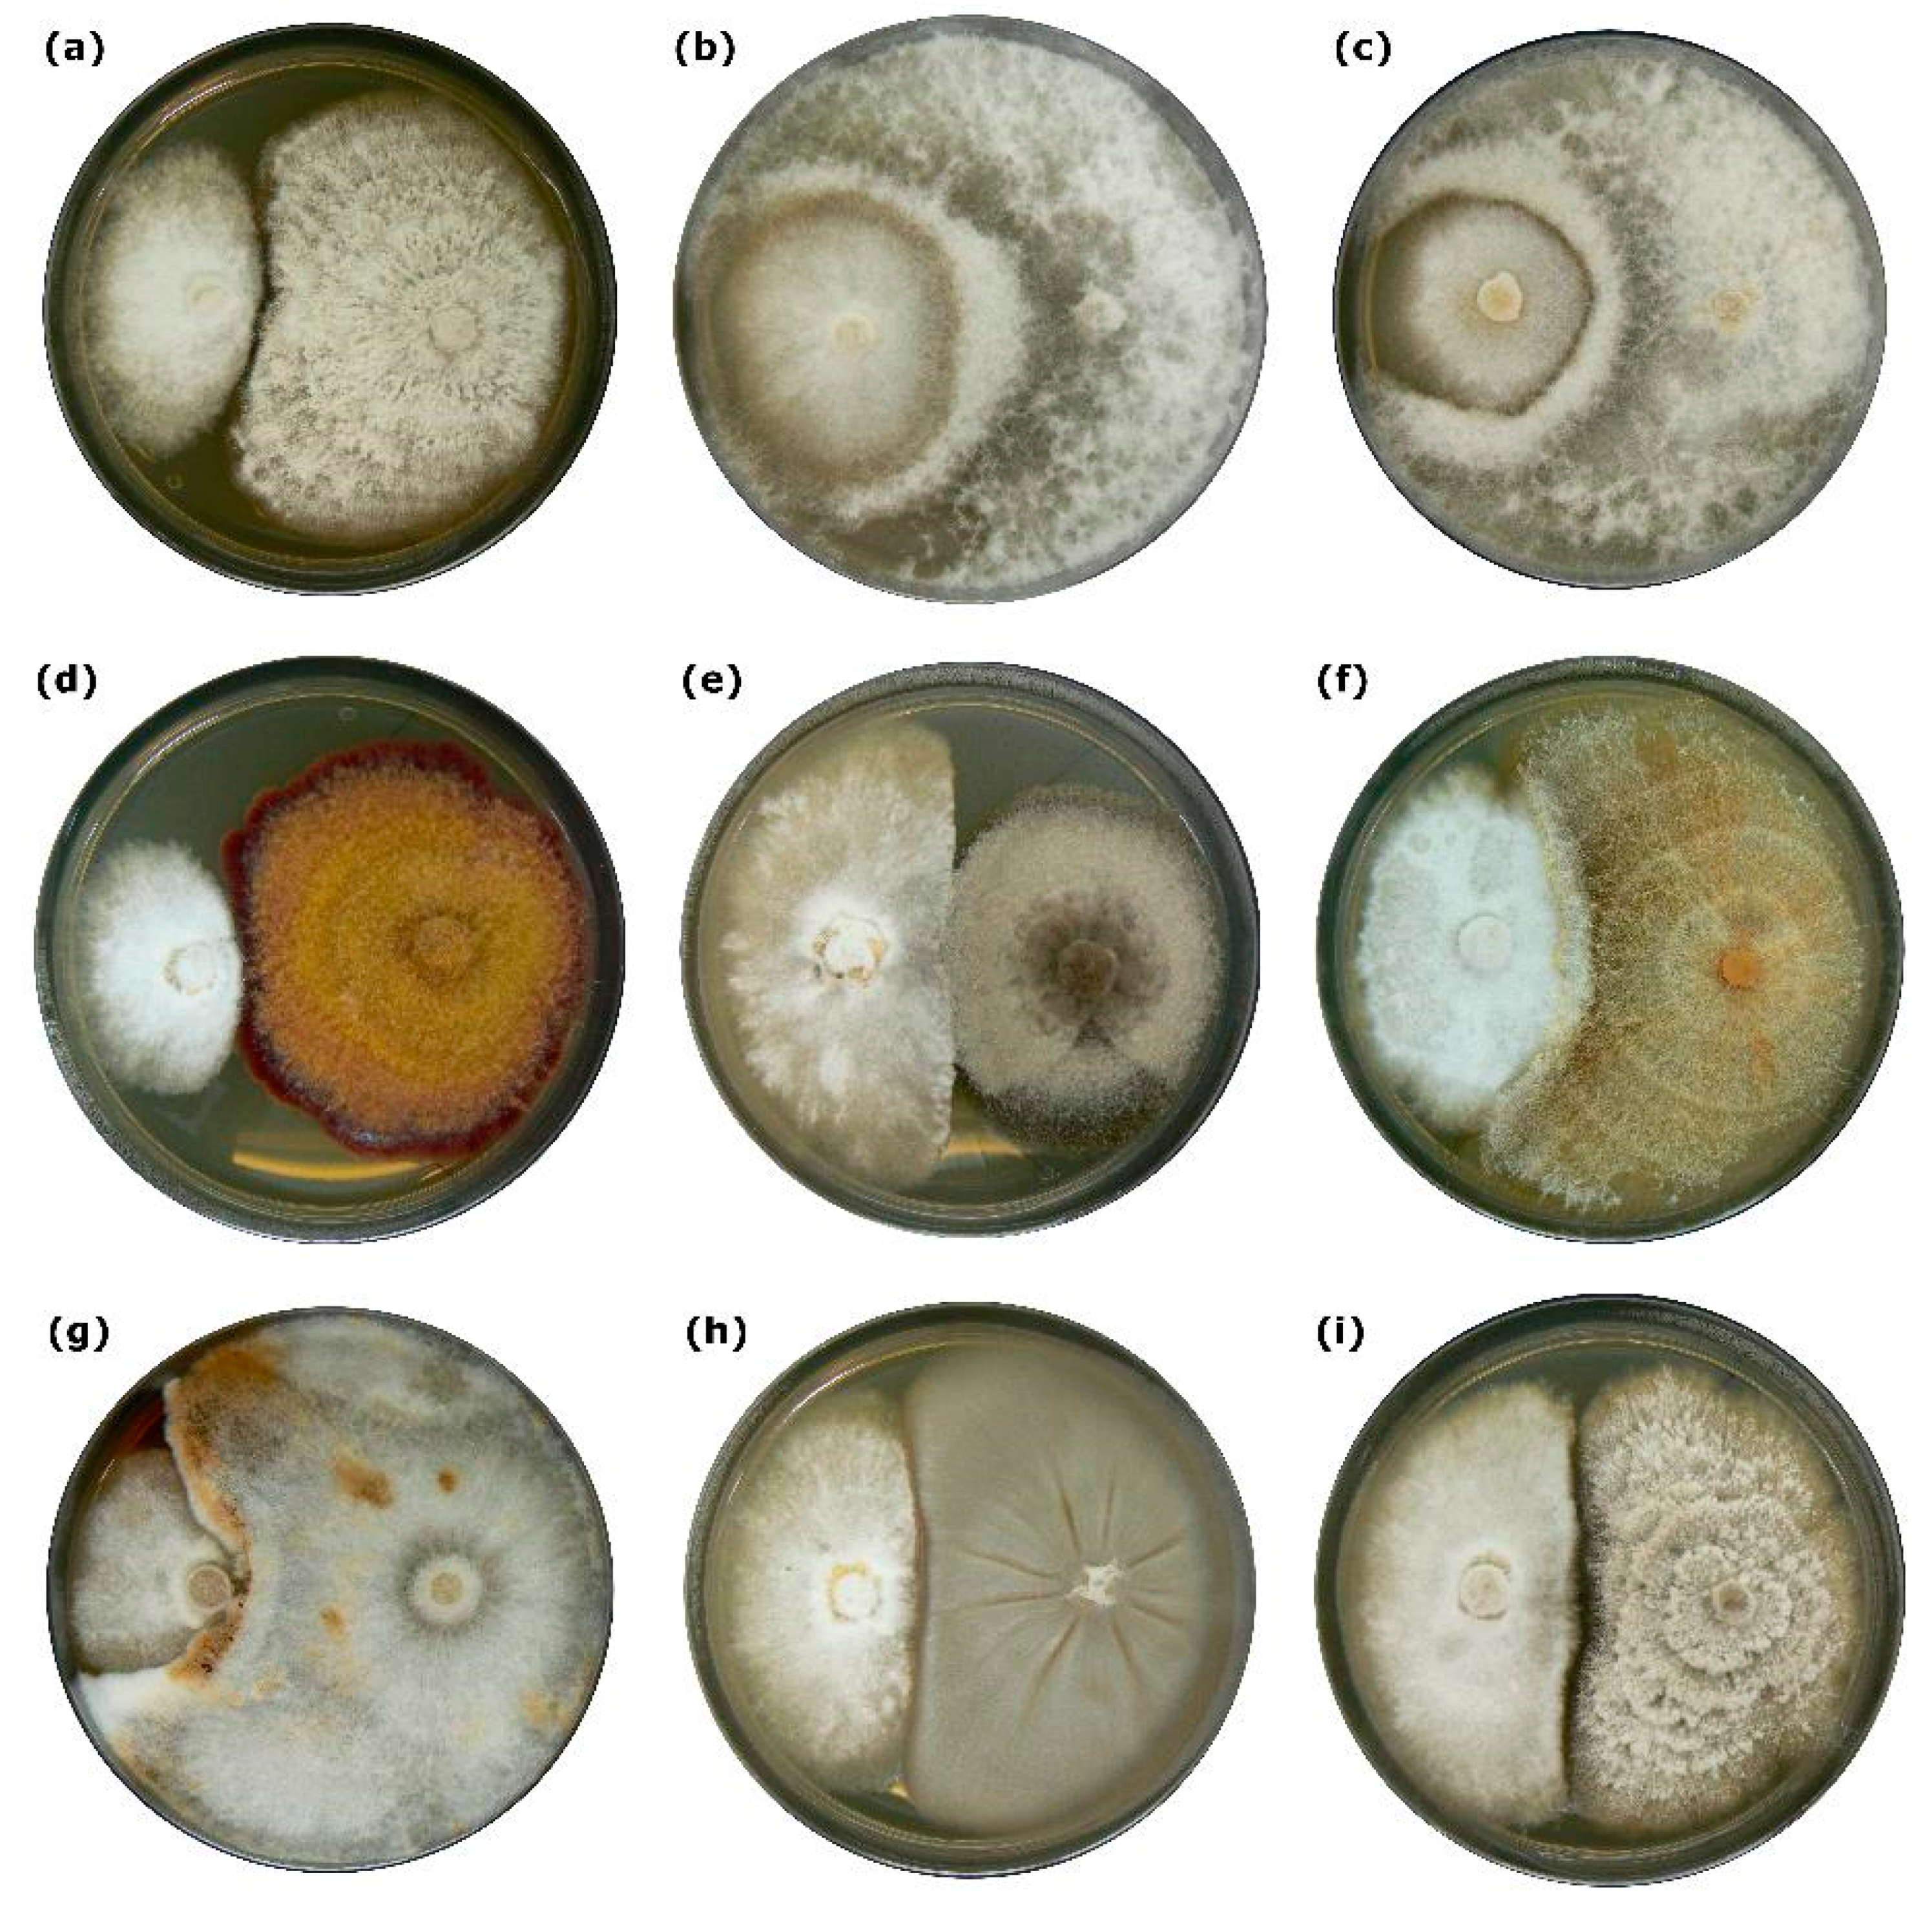
Forests 11 01072 g002 Forests 11 01072 g002
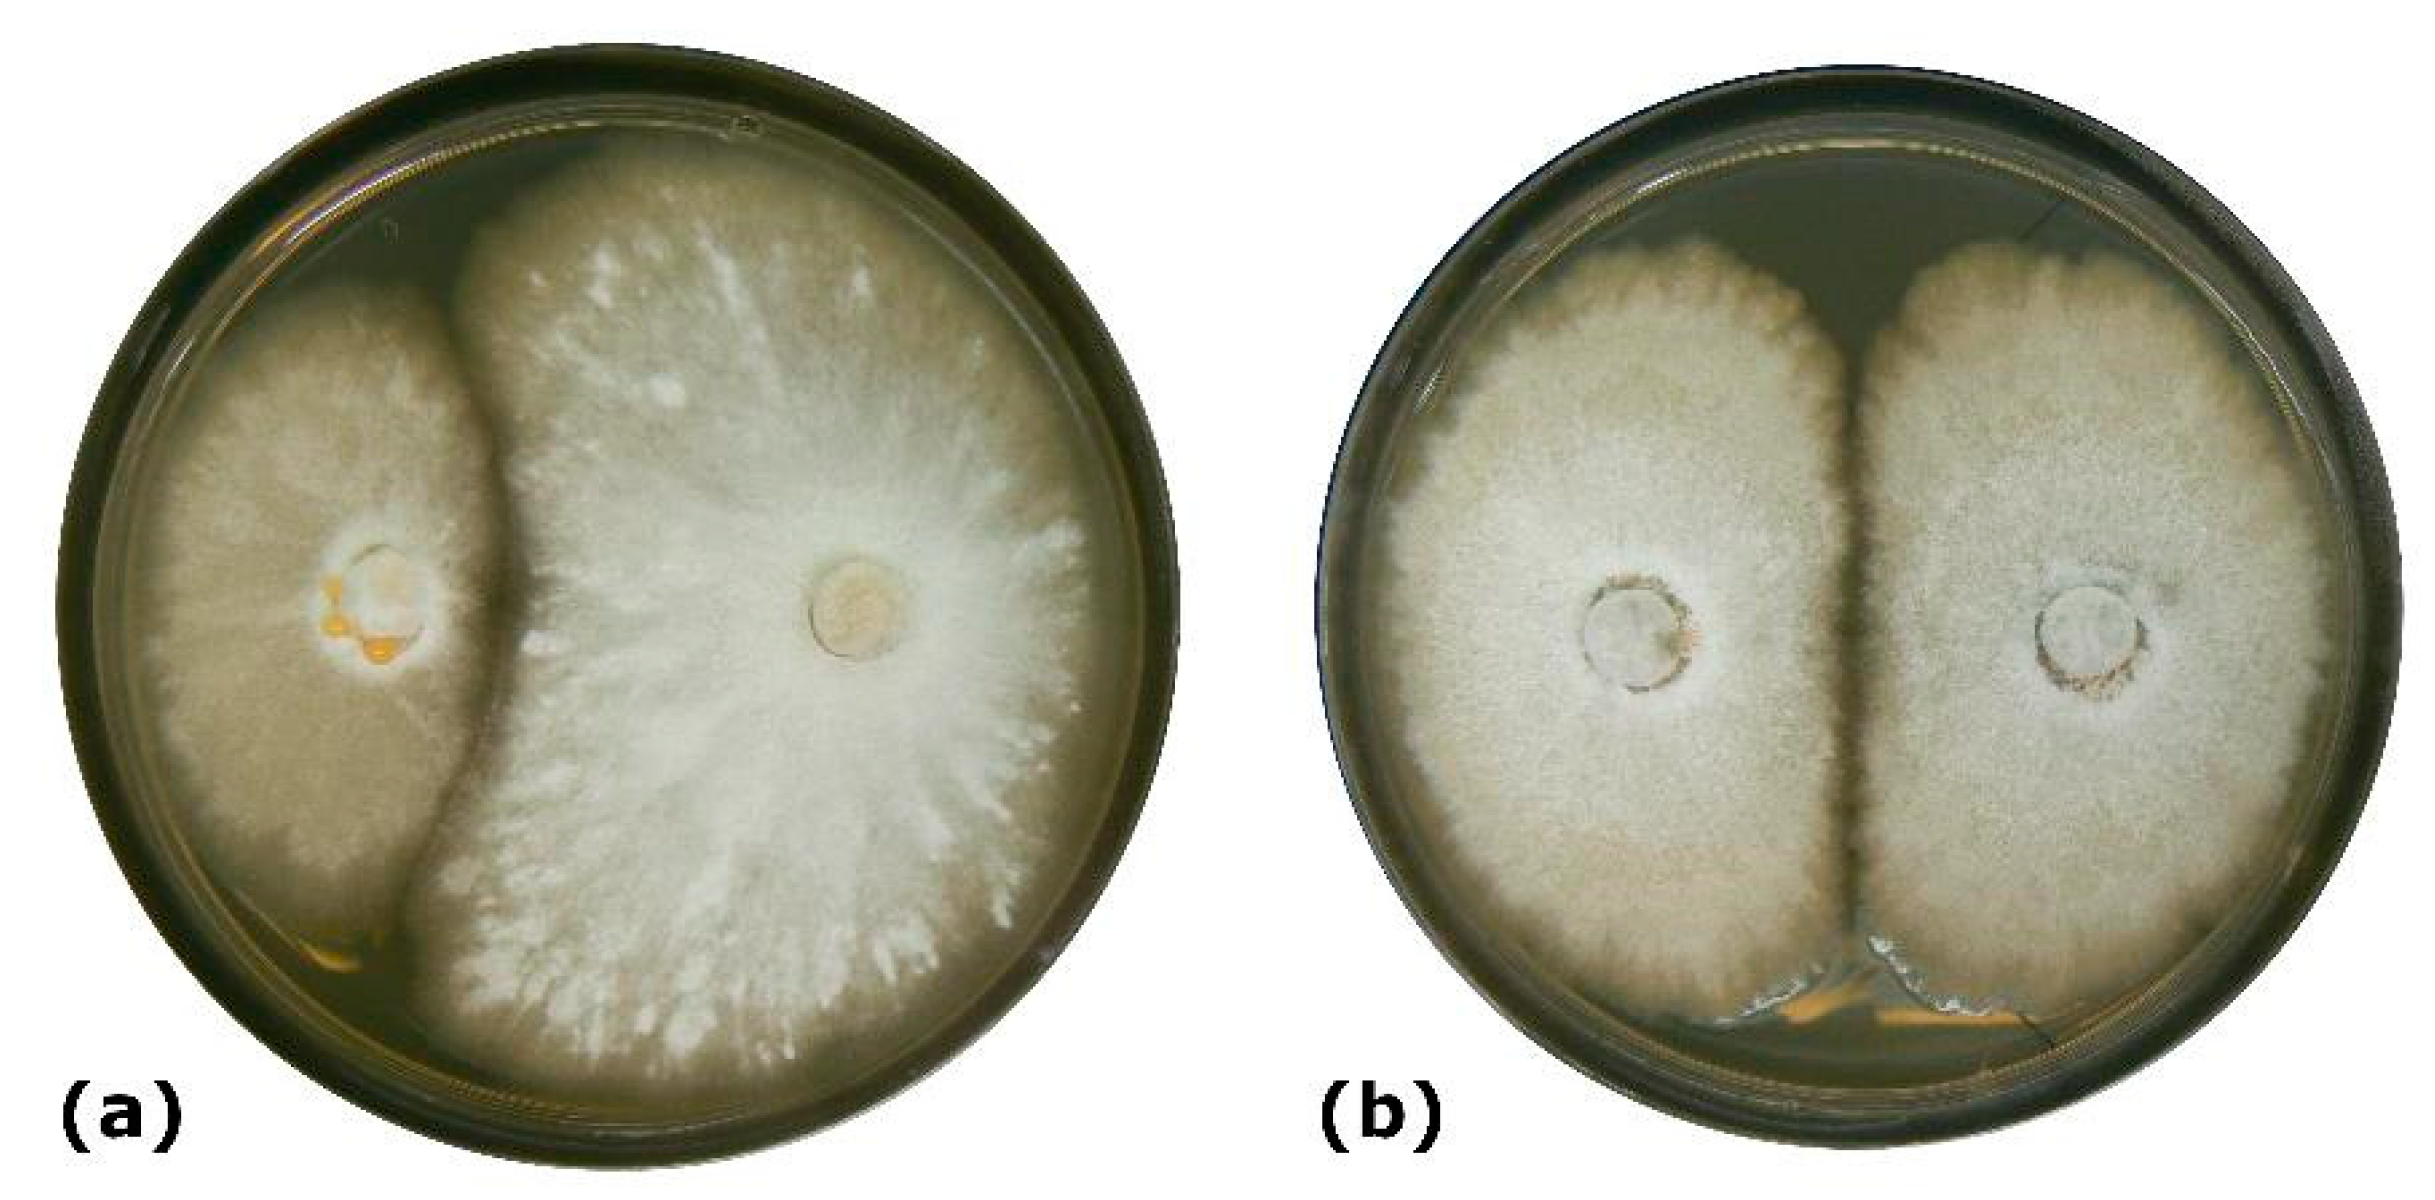
Forests 11 01072 g003 Forests 11 01072 g003

In Vitro Interactions between Eutypella parasitica and Some Frequently Isolated Fungi from the Wood of the Dead Branches of Young Sycamore Maple (Acer pseudoplatanus)
Abstract
1. Introduction
2. Materials and Methods
2.1. Interactions between E. parasitica and Ten Fungal Isolates in Dual Cultures
2.2. Re-Isolations from Dual Cultures
3. Results
3.1. Interactions between E. parasitica and Ten Fungal Isolates in Dual Cultures
3.2. Re-Isolations from Dual Cultures
4. Discussion
4.1. Interactions between E. parasitica and Ten Fungal Isolates in Dual Cultures
4.2. Re-Isolations from Dual Cultures
4.3. Summary of In Vitro Interactions between E. parasitica and Challenge Isolates
5. Conclusions
Author Contributions
Funding
Acknowledgments
Conflicts of Interest
References
- Falconer, R.E.; Brown, J.L.; White, N.A.; Crawford, J.W. Modelling interactions in fungi. J. R. Soc. Interface 2008, 5, 603–615. [Google Scholar] [CrossRef][Green Version]
- Badalyan, S.M.; Innocenti, G.; Garibyan, N.G. Interactions between xylotrophic mushrooms and mycoparasitic fungi in dual-culture experiments. Phytopathol. Mediterr. 2004, 43, 44–48. [Google Scholar]
- Yuen, T.K.; Hyde, K.D.; Hodgkiss, I.J. Interspecific Interactions among Tropical and Subtropical Freshwater Fungi. Microb. Ecol. 1999, 37, 257–262. [Google Scholar] [CrossRef]
- Hanácková, Z.; Havrdová, L.; Černý, L.; Zahradník, D.; Koukol, O. Fungal Endophytes in Ash Shoots—Diversity and Inhibition of Hymenoscyphus fraxineus. Balt. For. 2017, 23, 89–106. [Google Scholar]
- Bengtsson, S.B.K.; Barklund, P.; von Brömssen, C.; Stenlid, J. Seasonal Pattern of Lesion Development in Diseased Fraxinus excelsior Infected by Hymenoscyphus pseudoalbidus. PLoS ONE 2013, 9, e76429. [Google Scholar] [CrossRef] [PubMed]
- Bakys, R.; Vasaitis, R.; Barklund, P.; Ihrmark, K.; Stenlid, J. Investigations concerning the role of Chalara fraxinea in declining Fraxinus excelsior. Plant Pathol. 2009, 58, 284–292. [Google Scholar] [CrossRef]
- Heilmann-Clausen, J.; Boddy, L. Inhibition and Stimulation Effects in Communities of Wood Decay Fungi: Exudates from Colonized Wood Influence Growth by Other Species. Microb. Ecol. 2005, 49, 399–406. [Google Scholar] [CrossRef]
- Lacava, P.T.; Azavedo, J.L. Biological Control of Insect-Pest and Diseases by Endophytes. In Advances in Endophytic Research; Verma, V., Gange, A., Eds.; Springer: New Delhi, India, 2014; pp. 231–256. [Google Scholar]
- Viterbo, A.; Inbar, J.; Hadar, Y.; Chet, I. Plant Disease Biocontrol and Induced Resistance via Fungal Mycoparasites. In The Mycota IV. Environmental and Microbial Relationships; Kubicek, C.P., Druzhinina, I.S., Eds.; Springer: Berlin/Heidelberg, Germany, 2007; pp. 127–146. [Google Scholar]
- Rayner, A.D.M.; Griffith, G.S.; Wildman, H.G. Induction of metabolic and morphogenetic changes during mycelial interactions among species of higher fungi. Elicitors Plant Microb. Metab. 1994, 22, 389–394. [Google Scholar] [CrossRef]
- Hietala, A.M.; Korhonen, K.; Sen, R. An Unknown Mechanism Promotes Somatic Incompatibility in Ceratobasidium bicorne. Mycologia 2003, 95, 239–250. [Google Scholar] [CrossRef] [PubMed]
- Boddy, L. Interspecific combative interactions between wood-decaying basidiomycetes. FEMS Microbiol. Ecol. 2000, 31, 185–194. [Google Scholar] [CrossRef]
- Badalyan, S.M.; Innocenti, G.; Garibyan, N.G. Antagonistic activity of xylotrophic mushrooms against pathogenic fungi of cereals in dual culture. Phytopathol. Mediterr. 2002, 41, 200–225. [Google Scholar]
- White, N.A.; Boddy, L. Extracellular enzyme localization during interspecific fungal interactions. Fems Microbiol. Lett. 1992, 98, 75–80. [Google Scholar] [CrossRef]
- Evans, J.A.; Eyre, C.A.; Rogers, H.J.; Boddy, L.; Muller, C.T. Changes in volatile production during interspecific interactions between four wood rotting fungi growing in artificial media. Fungal Ecol. 2008, 1, 57–68. [Google Scholar] [CrossRef]
- Jurc, D.; Ogris, N.; Slippers, B.; Stenlid, J. First report of Eutypella canker of Acer pseudoplatanus in Europe. Plant Pathol. 2006, 55, 577. [Google Scholar] [CrossRef]
- Cech, T.L. Erstnachweis von Eutypella parasitica in Österreich. Forstsch. Aktuell 2007, 40, 10–13. [Google Scholar]
- Ogris, N.; Diminić, D.; Piškur, B.; Kraigher, H. First report of Eutypella parasitica causing cankers on field maple (Acer campestre) in Croatia. Plant Pathol. 2008, 57, 785. [Google Scholar] [CrossRef]
- Cech, T.L.; Schwanda, K.; Klosterhuber, M.; Straßer, L.; Kirisits, T. Eutypella canker of maple: First report from Germany and situation in Austria. For. Pathol. 2016, 46, 336–340. [Google Scholar] [CrossRef]
- Jurc, D.; Ogris, N.; Piškur, B.; Csóka, G. First report of Eutypella canker of maple (Eutypella parasitica) in Hungary. Plant Dis. 2016, 100, 1241. [Google Scholar] [CrossRef]
- Černý, K.; Hrabětová, M.; Svobodová, I.; Mrázková, M.; Kowalski, T. Eutypella parasitica naturalised in Bohemian and Polish Silesia. For. Pathol. 2017. [Google Scholar] [CrossRef]
- Bregant, C. Eutypella Parasitica: Primo Rinvenimento e Monitoraggio in Fruili Venezia Giulia. Master Thesis, Università degli Studi di Padova, Legnaro, Italy, 2018. [Google Scholar]
- Jurc, D.; Piškur, B.; Ogris, N.; Brglez, A.; Linaldeddu, B.T.; Bregant, C.; Montecchio, L. First report of Eutypella canker caused by Eutypella parasitica on Acer campestre in Italy. Plant Dis. 2019, 104. [Google Scholar] [CrossRef]
- Davidson, R.W.; Lorenz, R.C. Species of Eutypella and Schizoxylon associated with cankers of maple. Phytopathology 1938, 28, 733–745. [Google Scholar]
- Ogris, N.; Jurc, D.; Jurc, M. Spread risk of Eutypella canker of maple in Europe. Bull. Oepp/Eppo Bull. 2006, 36, 475–485. [Google Scholar] [CrossRef]
- French, W.J. Eutypella Canker on Species of Acer in New York State. Ph.D Thesis, State University College of Forestry at Syracuse University, Syracuse, NY, USA, 1967. [Google Scholar]
- Brglez, A.; Piškur, B.; Ogris, N. Eutypella parasitica and other frequently isolated fungi in wood of dead branches of young sycamore maple (Acer pseudoplatanus) in Slovenia. Forests 2020, 11, 467. [Google Scholar] [CrossRef]
- Tian, Y.; Tan, Y.; Liu, N.; Yan, Z.; Liao, Y.; Chen, J.; de Saeger, S.; Yang, H.; Zhang, Q.; Wu, A. Detoxification of Deoxynivalenol via Glycosylation Represents Novel Insights on Antagonistic Activities of Trichoderma when Confronted with Fusarium graminearum. Forests 2016, 8, 335. [Google Scholar] [CrossRef]
- Trivedi, S.; Srivastava, M.; Pandey, S.; Kumar, V.; Singh, A. Antagonism and Hyphal Relationship between Trichoderma spp. and Fusarium oxysporum-Rhizoctonia bataticola causing Wilt Complex in Chickpea. J. Pure Appl. Microbiol. 2016, 10, 1591–1598. [Google Scholar]
- López-González, R.C.; Gómez-Cornelio, S.; De la Rosa-García, S.C.; Garrido, E.; Oropeza-Mariano, O.; Heil, M.; Partida-Martínez, L.P. The age of lima bean leaves influences the richness and diversity of the endophytic fungal community, but not the antagonistic effect of endophytes against Colletotrichum lindemuthianum. Fungal Ecol. 2017, 26, 1–10. [Google Scholar] [CrossRef]
- Morón-Ríos, A.; Gómez-Cornelio, S.; Ortega-Morales, B.O.; De la Rosa-García, S.; Partida-Martínez, L.P.; Quintana, P.; Alayón-Gamboa, A.; Cappello-García, S.; Gonzáles-Gómez, S. Interactions between abundant fungal species influence the fungal community assemblage on limestone. PLoS ONE 2017, 12, e0188443. [Google Scholar] [CrossRef]
- Koukol, O.; Mrnka, L.; Kulhankova, A.; Vosatka, M. Competition of Scleroconidioma sphagnicola with fungi decomposing spruce litter needles. Can. J. Bot. 2006, 84, 469–476. [Google Scholar] [CrossRef]
- Piškur, B.; Ogris, N.; Jurc, D. Species-specific primers for Eutypella parasitica, the causal agent of Eutypella canker of maple. Plant Dis. 2007, 91, 1579–1584. [Google Scholar] [CrossRef]
- R Core Team. R: A Language and Environment for Statistical Computing, 3.6.1; R Foundation for Statistical Computing: Vienna, Austria, 2019; Available online: http://www.R-project.org (accessed on 17 September 2020).
- Fox, J.; Weisberg, S. An R Companion to Applied Regression, 3rd ed.; Sage: Thousand Oaks, CA, USA, 2019; Available online: https://socialsciences.mcmaster.ca/jfox/Books/Companion/ (accessed on 17 September 2020).
- Ogle, D.H.; Wheeler, P.; Dinno, A. FSA: Fisheries Stock Analysis. R Package Version 0.8.25. 2019. Available online: https://github.com/droglenc/FSA (accessed on 17 September 2020).
- Mangiafico, S. Rcompanion: Functions to Support Extension Education Program Evaluation. R Package Version 2.1.7. 2019. Available online: https://cran.r-project.org/web/packages/rcompanion/rcompanion.pdf (accessed on 17 September 2020).
- Kusari, P.; Kusari, S.; Spiteller, M.; Kayser, O. Endophytic fungi harbored in Cannabis sativa L.: Diversity and potential as biocontrol agents against host plant-specific phytopathogens. Fungal Divers. 2013, 60, 137–151. [Google Scholar] [CrossRef]
- Rezgui, A.; Vallance, J.; Ben Ghnaya-Chakroun, A.; Bruez, E.; Dridi, M.; Djidjou Demasse, R.; Rey, P.; Sadfi-Zouaoui, N. Study of Lasidiodiplodia pseudotheobromae, Neofusicoccum parvum and Schizophyllum commune, three pathogenic fungi associated with the Grapevine Trunk Diseases in the North of Tunisia. Eur. J. Plant Pathol. 2018, 152, 127–142. [Google Scholar] [CrossRef]
- Prior, R.; Feife, A.; Begerow, D. Antagonistic activity of the phyllosphere fungal community. Sydowia 2017, 69, 183–198. [Google Scholar]
- Asthana, A.; Shearer, C.A. Activity of Pseudohalonectria and Ophioceras. Mycologia 1990, 82, 554–561. [Google Scholar] [CrossRef]

| Fungal Isolate | Collection Number 2 | Number of Days 3 |
|---|---|---|
| Diaporthe sp. Nitschke | ZLVG 788 | 12 |
| Eutypa sp. Tul. & C. Tul. | ZLVG 790 | 7 |
| Eutypa maura (Fr.) Sacc. | ZLVG 789 | 5 |
| Eutypella parasitica R.W. Davidson & R.C. Lorenz | ZLVG 791 | 12 |
| Eutypella parasitica R.W. Davidson & R.C. Lorenz 4 | ZLVG 805 | 6 |
| Fusarium avenaceum (Fr.) Sacc. | ZLVG 792 | 12 |
| Neocucurbitaria acerina Wanas., Camporesi, E.B.G. Jones & K.D. Hyde | ZLVG 794 | — |
| Neonectria sp. Wollenw. | ZLVG 795 | 6 |
| Peniophora incarnata (Pers.) P. Karst. | ZLVG 797 | 5 |
| Petrakia irregularis Aa | ZLVG 798 | 14 |
| Phomopsis pustulata (Sacc.) Died. | ZLVG 799 | 7 |
| Label | Type of Interaction | Score |
|---|---|---|
| A | Deadlock 1 at mycelial contact | 1 |
| B | Deadlock at a distance, without mycelial contact | 2 |
| C | Replacement 2 | 3 |
| CA1 | Partial replacement after initial deadlock with mycelial contact | 3.5 |
| CB1 | Partial replacement after initial deadlock at a distance | 4 |
| CA2 | Complete replacement after initial deadlock with mycelial contact | 4.5 |
| CB2 | Complete replacement after initial deadlock at a distance | 5 |
| Fungal Isolate | Interaction Type 2 | AI | Statistic Group 4 |
|---|---|---|---|
| Diaporthe sp. | A 3 | 4 | ab |
| Eutypa sp. | CA1 | 10.5 | a |
| Eutypa maura | CA1 | 10.5 | a |
| Eutypella parasitica (ZLVG 791) | A | 3 | b |
| Eutypella parasitica (ZLVG 805) 1 | A | 3 | b |
| Fusarium avenaceum | A | 3 | b |
| Neocucurbitaria acerina | A 3 | 4 | ab |
| Neonectria sp. | CA1 | 10.5 | a |
| Peniophora incarnata | CA1 | 10.5 | a |
| Petrakia irregularis | A | 3 | b |
| Phomopsis pustulata | A | 3 | b |
© 2020 by the authors. Licensee MDPI, Basel, Switzerland. This article is an open access article distributed under the terms and conditions of the Creative Commons Attribution (CC BY) license (http://creativecommons.org/licenses/by/4.0/).
Share and Cite
Brglez, A.; Piškur, B.; Ogris, N. In Vitro Interactions between Eutypella parasitica and Some Frequently Isolated Fungi from the Wood of the Dead Branches of Young Sycamore Maple (Acer pseudoplatanus). Forests 2020, 11, 1072. https://doi.org/10.3390/f11101072
Brglez A, Piškur B, Ogris N. In Vitro Interactions between Eutypella parasitica and Some Frequently Isolated Fungi from the Wood of the Dead Branches of Young Sycamore Maple (Acer pseudoplatanus). Forests. 2020; 11(10):1072. https://doi.org/10.3390/f11101072
Chicago/Turabian StyleBrglez, Ana, Barbara Piškur, and Nikica Ogris. 2020. "In Vitro Interactions between Eutypella parasitica and Some Frequently Isolated Fungi from the Wood of the Dead Branches of Young Sycamore Maple (Acer pseudoplatanus)" Forests 11, no. 10: 1072. https://doi.org/10.3390/f11101072
APA StyleBrglez, A., Piškur, B., & Ogris, N. (2020). In Vitro Interactions between Eutypella parasitica and Some Frequently Isolated Fungi from the Wood of the Dead Branches of Young Sycamore Maple (Acer pseudoplatanus). Forests, 11(10), 1072. https://doi.org/10.3390/f11101072

